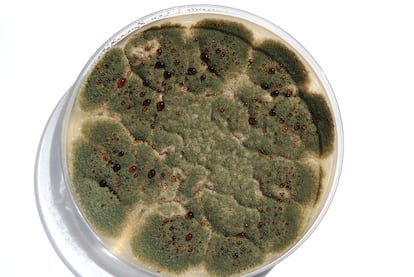

La resistencia a los antifúngicos y el calentamiento global han convertido a estos agentes infecciosos en una amenaza global emergente
'Histoplasma capsulatum' visto al microscopio con tinción de azul. La inhalación de sus esporas puede provocar histoplasmosis, una enfermedad infecciosa pulmonar y hematógena.ANA ALASTRUEY
ANA ALASTRUEY IZQUIERDO JUAN LUIS RODRÍGUEZ TUDELA
En el planeta Tierra, anualmente 6,5 millones de habitantes padecen una infección fúngica y 3,8 millones no la superan. En el año 1992 comenzaba su andadura en el Instituto de Salud Carlos III, en Madrid, lo que hoy es el Laboratorio de Referencia e Investigación en Micología. Si hoy la enfermedad fúngica es desconocida, en aquellos años únicamente se prestaba atención a ciertos hongos con los que se preparan platos muy apetitosos. Lo que nadie sospechaba es que eran asesinos sin conciencia ni remordimiento.
El VIH llevaba una década entre nosotros y, en los noventa, había alcanzado la categoría de pandemia. Las personas que viven con el VIH padecen diversas infecciones fúngicas que son extremadamente graves: la meningitis criptocócica, la histoplasmosis diseminada, la pneumocistosis y la talaromicosis. En los países de renta alta, la pandemia por el VIH consiguió controlarse y la creencia de que los antirretrovirales resolverían todos los problemas nos devolvió al ostracismo. Hoy se estima que, anualmente, 684.000 personas que viven con el virus padecen además, al menos, una de las enfermedades graves mencionadas más arriba y que un tercio de ellos no sobrevive. Si no se diagnostican, no se tratan y, si eso ocurre, más del 95% de los pacientes fallecen.
Los hongos adoran el calentamiento global, están envalentonados y viajan más, asentándose en áreas geográficas más amplias
En paralelo a la resolución parcial de la pandemia del VIH, los avances médicos auguraban un mejor pronóstico a las personas con cáncer, y sin duda acertaron, pero muchos son presa de la candidosis, la aspergilosis y otras osis que matan a ciertos pacientes que reciben anticancerígenos para controlar su enfermedad. Esta invasión también hace mella en los pacientes trasplantados. La revolución tecnológica que salva a muchos pacientes que antes fallecían, tiene como contraprestación las infecciones donde los hongos son protagonistas.
En 2009 nadie sospechaba que un hongo encontrado en el oído de un paciente japonés—Candida auris— iba a ocasionar una epidemia de proporciones inesperadas. Su capacidad para adherirse a cualquier superficie, unida a su multirresistencia a los antifúngicos y desinfectantes lo ha convertido en una pesadilla para multitud de hospitales que son incapaces de librarse de algo que parecía tan banal como su nombre: cándida. Ahora produce infecciones muy graves y difíciles de tratar por su resistencia a los antifúngicos.
Parecía que no aparecerían más contratiempos, pero una de las especies más amigables —Candida parapsilosis— decidió mutar y unirse al club de la resistencia. Hay hongos resistentes por todos lados, entre ellos uno cosmopolita, Aspergillus fumigatus. Los pesticidas juegan un papel importante en este rompecabezas, ya que se utilizan masivamente para eliminar los hongos que arruinan los cultivos agrícolas y las plantas de ornamentación. Un acuerdo global para limitar el uso de los que comparten mecanismos de acción con los utilizados para las micosis humanas ayudaría a la lucha contra la resistencia a los antifúngicos.
Colonia de 'Aspergillus', hongo causante de la aspergilosis -reacciones alérgicas e infecciones en los pulmones y otros órganos- creciendo en Agar extracto de Malta, que se usa para el cultivo de hongos.ANA ALASTRUEY
Además, los hongos adoran el calentamiento global, están envalentonados y viajan más, asentándose en áreas geográficas más amplias. Siempre han existido hongos que afectan a los animales y se transmiten a los humanos, pero nunca se había visto que un hongo ambiental, amante de las plantas, fuera capaz de saltar a un gato y generar una galopante epidemia en estos animales y sus dueños. La nueva especie Sporothrix brasiliensis se identificó en los años noventa en Brasil. Desde allí se ha extendido a Argentina, Bolivia, Colombia, Estados Unidos, Ecuador, Panamá, Paraguay, Perú y Venezuela.
La secuencia de calamidades continua con la aspergilosis pulmonar crónica, que ensombrece la calidad y esperanza de vida de pacientes que tienen enfermedades respiratorias crónicas y como guinda del pastel, los Mucorales, conocidos como los “hongos negros”, que adoran a los diabéticos descontrolados. Como colofón de plena actualidad, en tiempos de virus respiratorios, como es el invernal, también acechan a los que tienen la covid o gripe, causando muchas muertes.
Los hongos no solo nos asesinan, sino que muchos de los supervivientes quedan ciegos, amputados, desfigurados, asfixiados, en resumen, con multitud de secuelas que les impiden una vida plena.

Paciente sudanés con micetoma, una enfermedad tropical desatendida de la piel, causada por un hongo, que empieza por una pequeña úlcera que crece progresivamente y va consumiendo los tejidos, los músculos y los huesos.JORGE ALVAR
En el 2013 se fundó la ONG Global Action for Fungal Infections. En unión con otros científicos y sociedades profesionales, su incansable asesoría concienció a las instituciones globales para que analizaran el impacto en la salud pública de los hongos. Así, en octubre de 2022, la OMS publicó la primera lista de patógenos fúngicos prioritarios que pone las bases para fortalecer la respuesta global a las infecciones fúngicas y la resistencia a los antifúngicos. Asimismo, se han incluido algunas micosis en la lista de enfermedades tropicales olvidadas como el micetoma, la cromoblastomicosis y otras micosis profundas para establecer la política que impulse su prevención, diagnóstico y tratamiento.
Para nuestro planeta futuro, mantenemos la esperanza de que se consiga el acceso universal a su diagnóstico y tratamiento. Por sus consecuencias, esperamos que reciban la atención que se merecen y se destinen los suficientes fondos para salvar de la muerte, la dependencia y el estigma a millones de personas. Su colaboración es imprescindible: ya sabe, una gota de agua tras otra hace un océano, y un grano de arena tras otro un desierto… y una voz tras otra descubre lo oculto que se daba por olvidado. Confiamos que este artículo provoque una interminable cadena de luces que consiga sacar de la asesina oscuridad en la que los hongos se mueven.
____________________
Ana Alastruey Izquierdo es científica titular del Laboratorio de Referencia e Investigación en Micología del Instituto de Salud Carlos III, presidenta del consejo de dirección de WOMYC, de la asociación española de micología, y ha liderado el grupo de expertos que han elaborado la lista de patógenos fúngicos prioritarios de la OMS.
Juan Luis Rodríguez Tudela es fundador del Laboratorio de Referencia e Investigación en Micología del Instituto de Salud Carlos III, de la fundación GAFFI contra las infecciones fúngicas, y de la organización para la participación de mujeres en esta área de la ciencia, WOMYC. Actualmente es vicepresidente del consejo de dirección de GAFFI y patrono de WOMYC.
___________
Fuente:




